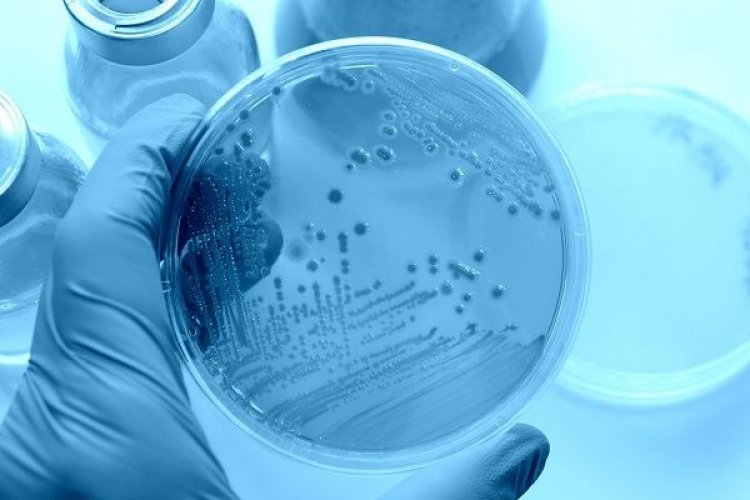
Ανακαλύφθηκαν ιοί που «παράγουν» ινσουλίνη

Ανακαλύφθηκαν ιοί που «παράγουν» ινσουλίνη
Πιστεύουν μάλιστα ότι η νέα αυτή ανακάλυψη θα ανοίξει νέους δρόμους στην ανακάλυψη των βιολογικών μηχανισμών που παίζουν ρόλο στην εκδήλωση
Πιστεύουν μάλιστα ότι η νέα αυτή ανακάλυψη θα ανοίξει νέους δρόμους στην ανακάλυψη των βιολογικών μηχανισμών που παίζουν ρόλο στην εκδήλωση του διαβήτη.
Οι επιστήμονες, με επικεφαλής εδικούς του Διαβητολογικού Κέντρου Joslin της Ιατρικής Σχολής του Χάρβαρντ, ανέλυσαν μια μεγάλη βάση δεδομένων με ιικές γονιδιακές αλληλουχίες. Έτσι εντόπισαν διάφορους ιούς που μπορούν να παράγουν πεπτίδια τα οποία μοιάζουν εν συνόλω ή εν μέρει με 16 ανθρώπινες ορμόνες και ρυθμιστικές πρωτεΐνες.
«Αυτό που μας τράβηξε την προσοχή ήταν τέσσερις ιοί της οικογένειας των Iridoviridae, που έχουν αλληλουχίες όμοιες με της ινσουλίνης», εξηγεί καθηγητής Ροναλντ Καν και συμπληρώνει ότι οι συγκεκριμένοι ιοί είναι γνωστό ότι προσβάλλουν τα ψάρια και τα αμφίβια, αλλά όχι τους ανθρώπους.
«Ωστόσο δεν αποκλείεται οι άνθρωποι να εκτίθενται σε αυτούς τους ιούς μέσω της κατανάλωσης ψαριών. Και κανείς μέχρι σήμερα δεν έχει ελέγξει κάτω υπό ποιες συνθήκες οι ιοί μπορούν είτε να μολύνουν τα κύτταρα ή εν μέρει τουλάχιστον να απορροφηθούν από το γαστρεντερικό σύστημα», τονίζει.
Για να ελέγξουν κατά πόσο οι ιοί είναι ενεργοί στα θηλαστικά, οι ερευνητές συνέθεσαν ιογενή πεπτίδια ινσουλίνης. Πειραματιζόμενοι με ποντίκια και κύτταρα ανθρώπων, θέλησαν να δουν αν όντως δρουν όπως οι ορμόνες.
Τα πειράματα έδειξαν πράγματι ότι τα ιογενή πεπτίδια ινσουλίνης προσδένονται στους ανθρώπινους υποδοχείς ινσουλίνης και σε υποδοχείς που σχετίζονται με τον ινσουλινοειδή αυξητικό παράγοντα 1 (IGF-1). Πρόκειται για καίριας σημασίας πρωτεΐνες που λένε στα κύτταρα να απορροφήσουν την γλυκόζη και να συνεχίσουν να αναπτύσσονται.
Επιπλέον τα πεπτίδια μπορούσαν να διεγείρουν όλες τις οδούς σηματοδότησης εντός των κυττάρων που είχαν διεγερθεί από τον ανθρώπινο ινσουλινοειδή αυξητικό παράγονα 1.
Στα ποντίκια που έγινε η έγχυση των πεπτιδίων παρουσίασαν στη συνέχεια χαμηλά επίπεδα γλυκόζης στο αίμα, άλλη μια απόδειξη της δράσης της ινσουλίνης.
Περαιτέρω αναλύσεις των βάσεων δεδομένων για τους ιούς έδειξαν ότι στο ανθρώπινο έντερο υπάρχουν όντως αποδείξεις ότι οι άνθρωποι έχουν εκτεθεί σε τέτοιους ιούς. «Οι ιοί αυτοί είναι μόνο η κορυφή του παγόβουνου. Πιστεύεται ότι υπάρχουν πάνω από 300.000 ιοί που μπορούν να μολύνουν ή να διαδοθούν μέσω των θηλαστικών και μόνο 7.500 περίπου έχουν αναλυθεί. Συνεπώς, περιμένουμε να βρούμε και άλλες ιογενείς ορμόνες, περιλαμβανομένων και περισσότερων ιογενών ινσουλινών, στο εγγύς μέλλον. Η έρευνα αυτή απλά ανοίγει τον δρόμο για μια νέα διερεύνηση του διαβήτη τύπου 1 και της αυτοανοσίας», λέει ο Δρ Καν.
health.in.gr
























![Postal Voting Procedures: Καθορισμός διαδικασιών και όρων επιστολικής ψήφου - Όλα όσα πρέπει να γνωρίζετε [Έγγραφα]](https://www.mykonosticker.com/uploads/images/2026/04/image_705x436_69e3af84d8efc.jpg)